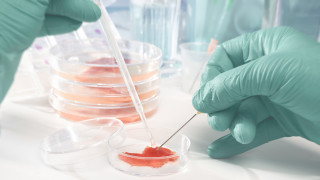
За първи път одобриха продажбата на култивирано месо произведено в

... симптоми да са диария и повръщане, при тежки случаи може да се стигне до ампутации, а един на всеки пет пациенти умира, предупреждават от CDC.
Консумация Месо - Новини
Невероятната история на популярния в Южна Африка лечител и шаман
...... някакъв силен и дългодействащ наркотик. Обаче такива ефекти не се наблюдават при нито едно известно наркотично вещество, включително и при халюциногенните гъби. Източник: Уикенд
Ново проучване установи че пациентите диагностицирани с Алцхаймер са склонни
...... която се смята за причина за .Според неправителствената организация Alzheimer Europe повече от 7,8 милиона граждани на ЕС са живели с деменция през 2018 г.
Над 30 души са се заразили с трихинелоза след консумация
...... яйцата да не са били подложени на ветеринарно-медицински контрол е сериозна, което от своя страна е предпоставка за здравен риск при консумацията на такива храни.
Ново изследване на учени от Северозападния университет установи консумацията на
...... на преработени меса (салами, наденици и др.) Единствено здравословна и без никакви рискове си остава рибата, но тя много често отсъства от менюто на обикновения човек./zdrave.to
Опасно за здравето месо се продава в страни от Европейския
...... почти всички заболели в Австрия са яли пилешко малко преди това. По-нататъшни разследвания показват, че всички засегнати ресторанти са използвали пилешко месо за шишчета, внесено от Полша.
Европейските здравни власти са регистрирали най малко 134 случая на салмонела които
...... почти всички заболели в Австрия са яли пилешко малко преди това. По-нататъшни разследвания показват, че всички засегнати ресторанти са използвали пилешко месо за шишчета, внесено от Полша.
Американското министерство на земеделието и Агенцията по храните и лекарствата
...... но и свинско, агнешко, риба и говеждо месо, тъй като въздействието на традиционната консумация на месо върху околната среда е най-силно изразено при говеждото месо.
През 2022 г линията на бедност общо за страната e
...... предходната година се наблюдава в областите Плевен (с 13.9%), Шумен (с 11.4%), Разград (с 10.1%), Бургас (с 3.6%), Пловдив (с 2.4%) и Благоевград (с 0.6%)
Дългият великденски пост за пречистване на организма ще ви донесе
...... докато организмът ви се върне в нормалното си темпо. Узнайте още кои хора не бива да консумират месо и кои са добрите заместители на месото.
Ценителите на добрата храна казват че ястията с полусурово месо
...... на месото е задължителна. Това важи особено за рисковите групи, но също и за всеки човек, който е загрижен за здравето на храносмилателната си система.
Търсенето на месо и други животински продукти в световен мащаб
...... Processed Meat. In IARC Monographs. Vol:114. Katare B., Wang H.H., Lawing J., Hao N., Park T., Wetzstein M. 2020. Toward Optimal Meat Consumption. American Journal of Agricultural Economics. 102(2):662–680.
САЩ одобриха за консумация създадено в лаборатория месо Американската агенция
...... одобрение и се отнася само за продукти на „UPSIDE“. /БГНЕС Зеленски: Вярвам, че ракетата, паднала в Полша, е руска BGNES САЩ одобриха за консумация създадено в лаборатория месо
Американската агенция по храните и лекарствата за първи път одобри
...... храните и лекарствата заяви, че е прегледала данните на компанията и няма допълнителни въпроси относно заключението, че нейният продукт е безопасен за консумация от хора.
Американската агенция по храните и лекарствата за първи път одобри
...... храните и лекарствата заяви, че е прегледала данните на компанията и няма допълнителни въпроси относно заключението, че нейният продукт е безопасен за консумация от хора.
Месото е пилешко култивирано чрез клетки от живи животни които
...... храните и лекарствата заяви, че е прегледала данните на компанията и няма допълнителни въпроси относно заключението, че нейният продукт е безопасен за консумация от хора.
Американската агенция по храните и лекарствата за първи път одобри за
...... по храните и лекарствата заяви, че е прегледала данните на компанията и няма допълнителни въпроси относно заключението, че нейният продукт е безопасен за консумация от хора.
UPSIDE Foods е компанията която произвежда пилешко месо култивирано чрез
...... относно заключението на компанията, че нейният продукт е безопасен за консумация от хора. Прегледът технически не е одобрение и се отнася само за продукти на „UPSIDE“.
Американската агенция по храните и лекарствата FDA за първи път
...... заключението на компанията, че нейният продукт е безопасен за консумация от хора. Прегледът технически не е одобрение и се отнася само за продукти на „UPSIDE“.
Американската агенция по храните и лекарствата FDA за първи път
...... заключението на компанията, че нейният продукт е безопасен за консумация от хора.Прегледът технически не е одобрение и се отнася само за продукти на „UPSIDE“. /БГНЕС
Настоящият начин на производство на храни застрашава бъдещите глобални доставки
...... тези промени заедно биха могли да допринесат значително за осигуряване на нарастващото търсене на храни по устойчив начин без значително увеличение на цените, заключава проучването.
Ново изследване прецизира рисковете от консумация на червено месо съобщава
...... риск от болести. Американският институт за здравни показатели и оценки възнамерява да приложи системата си за оценяване на риска при алкохолна консумация и замърсяване на въздуха.
На фона на по нататъшното нарастване на световното население е спешно
...... доставка. Всичко това заедно може да допринесе значително за устойчивото осигуряване на нарастващото търсене на храни без значително повишаване на цените, се казва в проучването.
Българската агенция по безопасност на храните БАБХ насочи за унищожаване
...... от развитие на патогенни микроорганизми и риск за здравето на потребителите, поради което цялата пратка от месото е поставено под възбрана и насочено за унищожаване.
Д р Цветан Гатев е ендокринолог в УМБАЛ Александровска Завършил е
...... от нашето ежедневие! Материалът има информативен характер и не може да замести консултацията с лекар. Преди да предприемете лечение, задължително се консултирайте с лекар.
37 от произведения от човешка дейност метан идва от животновъдството
...... здраве и прилагане на политики, които насърчават здравословното хранене, което е достъпно, безопасно, удобно и най-вече вкусно. Защото това, което ядем, има значение. Статия на
37 от произведения от човешка дейност метан идва от животновъдството
...... общественото здраве и прилагане на политики, които насърчават здравословното хранене, което е достъпно, безопасно, удобно и най-вече вкусно. Защото това, което ядем, има значение. Статия на
Пристрастеността към месото особено към червеното и обработеното като наденички
...... приятел вегетарианец. Когато най-сетне отново успеем да поканим гости, ще можем да организираме изцяло вегетарианско пиршество, което ще зарадва дори поканените любители на месо.
Държавните медии в Северна Корея започват масирана кампания която информира
...... Ким Чен Ун наскоро призна, че ситуацията с изхранването на населението в Северна Корея е "напрегната", но отрече информацията на ООН за хиляди гладуващи хора.
Служители на ОД на МВР Пазарджик и инспектори от Областната дирекция
...... от животински произход. Всички открити количества са поставени под възбрана от инспекторите от Областната дирекция по безопасност на храните. Издадено е и предписание за унищожаването им.
Близо 4 тона месо с изтекъл срок на годност са
...... разфасовки от близо 3600 кг пилешки фенер, които били неетикетирани и негодни за консумация, предаде БНТ.Дадено е предписание за унищожаване на месните продукти.По публикацията работи:
Голямо количество месо и месни продукти са под възбрана след
...... кг пилешки фенер, които били неетикетирани и негодни за консумация.Всички количества за поставени под възбрана от инспекторите от ОДБХ. Дадено е предписание за унищожаването им.
Голямо количество месо и месни продукти са под възбрана след
...... кг пилешки фенер, които били неетикетирани и негодни за консумация.Всички количества за поставени под възбрана от инспекторите от ОДБХ. Дадено е предписание за унищожаването им.
Потреблението на свинско месо в Русия през първата година от
...... г. ще се увеличи със 170 хил. тона и ще достигне нов връх - 4,44 млн. тона, което е с 4% повече спрямо 2020 г.
Червеното месо е сред най консумираните в световен мащаб Към него
...... месо имат по-висок риск от сърдечносъдови инциденти и високо кръвно налягане, сочат данните от проучване от 2016 година, публикувано в Public Health Nutrition.По публикацията работи:
Пилешкото месо е сред най разпространените в световната кухня най вече заради широко
...... Проблемът е, че редовната им консумация, ни прави резистентни към лекарствата, с които ги тъпчат. Разболеем ли се, въпросните лекарства просто няма да ни подействат.
За първи път одобриха продажбата на култивирано месо произведено в
...... следователно въглеродни емисии. Но производителите уверяват, че щом се засили производството на култивирано месо, ще паднат емисиите и ще се използва по-малко вода и земя.
Хранителните навици на всеки човек са различни Някои се въздържат
...... виновник за синтеза на колаген – протеин, който изгражда структурите в кожата и косата.Още по темата може да прочетете в Az-jenata.bgПо публикацията работи: Михаела Лазарова
Повишеното ниво на пикочна киселина в организма е свързано и
...... на пикочна киселина в кръвта по-малка от 360 мкмол/л или 6 мг/дл. До какво води прекалената консумация на месо и бира вижте на Zdrave.to
Смяна на човешката диета в полза на растителни продукти може
...... Смит, учени от Университета в Абърдийн.Докладът зове още за енергични действия срещу нанасянето на щети на почвата и обезлесяването, които допринасят за климатичните промени. /БНР
Дори малките количества червено месо в диетата увеличават риска от
...... месо въобще, тези, които са консумирали малко, са имали по-висок риск от преждевременна смърт поради различни причини или от сърдечно-съдови заболявания“, сочат заключенията на експертите./zdrave.to
Ако човек иска да отслабне трябва да консумира големи количества
...... полза от месната диета е понижаването нивото на холестерола. Специалистите отбелязват, че до подобни резултати води сготвянето на месо, без използване на голямо количество мазнина
По повод активното разпространение на болестта африканска чума по свинете
...... и яйца не е опасна за човека. Ранно откриване и своевременно унищожаване на заразени стада птици е ключов елемент за контрола и ликвидирането на болестта.
По повод активното разпространение на болестта африканска чума по свинете
...... не е опасна за човека. Ранно откриване и своевременно унищожаване на заразени стада птици е ключов елемент за контрола и ликвидирането на болестта.
Българската агенция за безопасност на храните забрани вноса на продукти
...... и яйца не е опасна за човека. Ранно откриване и своевременно унищожаване на заразени стада птици е ключов елемент за контрола и ликвидирането на болестта.
В България вече няма да може да се внася храна
...... за да се намали популацията им, тъй като те също са преносители на заразата. Заболяването не е опасно за хората, отбелязват от Агенцията по храните.
В България вече няма да може да се внася храна
...... за да се намали популацията им, тъй като те също са преносители на заразата. Заболяването не е опасно за хората, отбелязват от Агенцията по храните.
Тениозата е медицински термин с който се означава заболяването причинено
...... пациентите с цистицеркоза (когато те са междинни гостоприемници на паразита) се налага диспансеризация за срок от 2 години и периодни клинични прегледи и лабораторни изследвания.